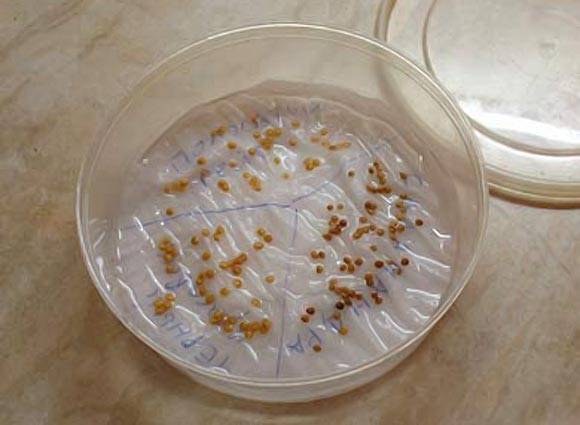

Content
Tomato with a rather unusual name Klusha gained popularity among vegetable growers due to the compact structure of the bush and the early ripening of the fruits. In addition to these qualities, a large yield is added. The plant forms clusters with a record number of fruits. The variety was bred by domestic breeders. More precisely, it turned out to be two crops with different fruit colors. The red color of the flesh is the Klusha tomato, and the pink tomatoes are dubbed Super Kluche.
Description of the variety
The main characteristics and description of varieties of Klush tomato and Super Klush are the same. In principle, they are one and the same culture. The only difference is the color of the fruit and, of course, their taste. But let's start the review with the timing of ripening. Klusha tomatoes are ripened very early. From the moment of sowing the seeds, it will take about 90 days, and the fruits hanging in large brushes will already turn red on the garden bed.
The plant is considered a determinant type. The structure of the bush is standard. Stems grow up to a maximum of 60 cm in height. An adult tomato bush is so compact that on a 1 m garden bed2 fits up to 7 plants. Klushu can even be grown on a windowsill or balcony. The culture bears excellent fruit in a flower pot suspended with a planter.
You can guess the origin of the variety name by the structure of the bush. If you look at the Super Klusha tomato from the side, then its shape resembles a chicken with spread feathers. The fruits hidden under the leaves can be compared to chickens. The plant is a master of hide and seek. Ripening tomatoes are almost invisible under the foliage. The bush is distinguished by its thickened green mass. The structure of the leaf is common, like all tomatoes.
The manufacturer in the description of the Klusha tomato variety indicates that the crop can be grown in all regions of our country. Breeders have instilled in the tomato a good immunity to fungal and viral diseases. Optimum yield of Klushi and Super Kluzhi is achieved when the bush is formed with several stems. Their number can be from 2 to 4.
The compact bush is characterized by strong stems that do not require a tie to the trellis. But if you read reviews about the Super Klusha tomato, then vegetable growers strongly recommend putting props under the branches with fruits.
Fruit characteristics
About the Klusha tomato photo, reviews of gardeners form the opinion that culture is a decoration of the garden. The fruits are characterized by a round shape. The upper part and the wall at the point of attachment of the peduncle are slightly flattened. In the Klusha variety, the red color of the fruit predominates, and the Super Klusha tomatoes, when ripe, acquire a pink tint. The flesh of both varieties of tomato is sweet, juicy and delicious when eaten fresh. Up to 7 chambers with seeds can be located inside the fruit.
Despite the small size of the bush, the yield indicator is up to 3 kg of tomato per plant. Klusha loves compliance with the conditions of agricultural technology. The crop will thank for good care with fruits weighing up to 150 g. Under unfavorable conditions for the tomato, the yield indicator may decrease. The fruits will become smaller as their weight drops to 100 g.
Ripe fruits are considered to be of universal use. Tomatoes are suitable for fresh consumption. They make salads, decorate dishes. According to the reviews of vegetable growers, it is the pink fruits of the Super Klusha variety that are considered tastier. Red tomatoes of the Klusha variety are slightly inferior in taste. However, a mature vegetable is also good for fresh salads. Red and pink fruits are preserved. The dense pulp, protected by a strong skin, does not crack during heat treatment.
Positive features of the variety
Considering the yield of the Super Klusha tomato, reviews, photos, let's summarize the main advantages of the variety:
- a small bush can fit on a small piece of land;
- high yield rate;
- independent formation of the bush, which does not require the removal of stepchildren;
- Klushi fruits are universal in application;
- plant resistance to diseases;
- the possibility of growing tomatoes in any regions of the country.
Vegetable growers did not reveal any drawbacks in the Klusha and Super Klusha varieties. This can only include a strong foliage thickening, but in the hot summer it will save the fruits from burns.
Choosing a place for planting tomatoes
To get a good harvest, tomatoes need to be planted in a prepared area. The garden bed must be allocated, even if the tomatoes are grown in the garden. Klusha has a low-growing bush structure, so the plants can be planted in the holes. Although, many gardeners prefer to dig long grooves. Tomatoes are neatly arranged in rows and easier to care for.
The Klusha and Super Klusha varieties can be grown not only openly, but also in a closed way. Tomato bears fruit perfectly in any type of greenhouse, be it a film cover, glass or polycarbonate. It is only important to provide the tomatoes with good lighting and regular airing.
With any method of growing a Klush tomato, you need to take care of good soil drainage. The culture loves abundant watering, but the water should not stagnate under the roots. Otherwise, outbreaks of disease are possible. Late blight will appear or plant roots will begin to rot.
Soil preparation for seedlings
In most regions, tomatoes are grown from seedlings. Only in the south is it allowed to sow seeds directly to the garden. To grow seedlings of Klush or Super Klush tomatoes, you first need to prepare the soil. Despite the saturation of the store soil with useful minerals, many vegetable growers prefer to collect land from the garden for seedlings. You can do that, only it needs to be disinfected. It is recommended to bake the soil in the oven, and then take it out to fresh air. On the street, the soil will be saturated with oxygen for two weeks.
Before sowing seeds, the soil is brought into the house so that it warms up to room temperature. At this time, another disinfection is performed. A solution is prepared from 2 liters of water and 1 g of manganese and the earth is evenly moistened with this liquid.
Seed preparation
Sowing seeds of a Klush tomato for seedlings is carried out in March. By this time, the grains need to be prepared:
- The seed germination percentage depends on the calibration. First, the tomato grains are visually inspected for damage and all suspicious seeds are discarded. The following procedure involves immersing tomato seeds in a saline solution. All floating pacifiers are thrown away, and the full grains that have settled to the bottom of the container are washed with clean water.
- The pickling of tomato seeds is carried out in a 1% manganese solution. It is enough to dip the grain for 20 minutes. Many vegetable growers use the juice of the indoor flower Aloe instead of potassium permanganate. In addition to disinfecting properties, juice is a growth stimulant.
The last stage involves the germination of tomato seeds.To do this, the grains are scattered between two layers of wet gauze and make sure that they do not dry out. Tomato seeds are periodically sprayed with water until sprouts hatch.
Sowing seeds and getting seedlings
After all the tomato seeds have sprouted, they must be planted immediately. By this time, containers with soil should be prepared. On the surface of the earth, any object or finger of the hand makes grooves 1 cm deep. The distance between the rows is maintained within 2-3 cm. Tomato seeds are laid out in 3 cm steps, after which they are sprinkled with loose soil on top and sprayed with water.
The containers are covered with a transparent film. In this state, they stand at an air temperature of +25aboutFrom to germination. After the tomatoes sprout, the film is removed and the seedlings are provided with good lighting. When two full-fledged leaves grow on the tomatoes, the plants dive in cups and on the third day they are fed.
Landing on a permanent place of growth
Adult tomato seedlings are hardened before planting. Tomatoes are taken outside when the air temperature is at least +18aboutC. It is advisable to perform such procedures for about a week. Planting tomato Clushi begins at 50-60 days of age. By this time, the plants are stretched up to 30 cm in height.
The time for planting tomatoes in the greenhouse falls in the first ten days of May. In the garden, Klusha tomatoes are planted after the establishment of warm weather and the warming up of the soil. For the middle lane, this period occurs in the last days of May. Variety Super Klusha and Klusha love loose, well-fertilized soil. It is better to let the acidity be slightly increased than decreased. In extreme cases, a neutral indicator is allowed. Determinant tomatoes do not stretch, therefore, when planting seedlings, the roots should not be buried. 1 m2 it is optimal to plant five bushes.
Adult tomato care
The Klusha variety does not require special care. Timely watering, weeding is important weeds, loosening the soil. 3 weeks after planting the seedlings, the tomatoes are fed with nitroammophos fertilizer. Bushes do not require step-sons. But if the plants themselves are poorly formed, the vegetable grower can have a hand. The bushes are helped to form into 2-4 stems by breaking off unnecessary stepchildren. In the case of strong thickening, some of the foliage is removed from the tomato.
When cultivated in a closed way, the air humidity is lowered during flowering for better pollination. At the same time, the air temperature is kept at a maximum of +28aboutFROM.
The video tells about tomatoes for open ground:
It is best to start harvesting when the fruit is just starting to turn red or pink. For long-term storage, each tomato can be wrapped in soft paper and laid out in drawers.
Testimonials
And now let's read reviews of gardeners about the Klusha tomato.